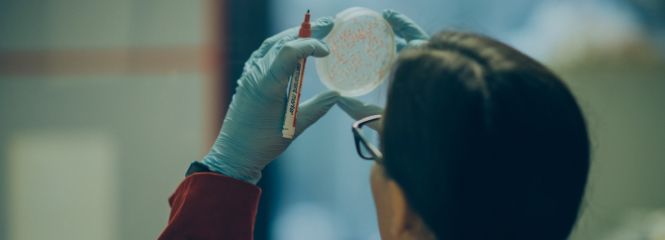

Weitere Inhalte
Mehr laden
von
Studium
Evidenzbasierte Medizin
PhD Applied Evidence Synthesis in Health Research
Doctor of Philosophy, 6 Semester
Zu Favoriten hinzufügen
Gesundheitsförderung & Sozialwesen
Suchtberatung – Grundlagen und praktische Anwendung
NeuTeilnahmebestätigung, 2 Tage
Zu Favoriten hinzufügen
News & Presse
Veranstaltungen
Personen